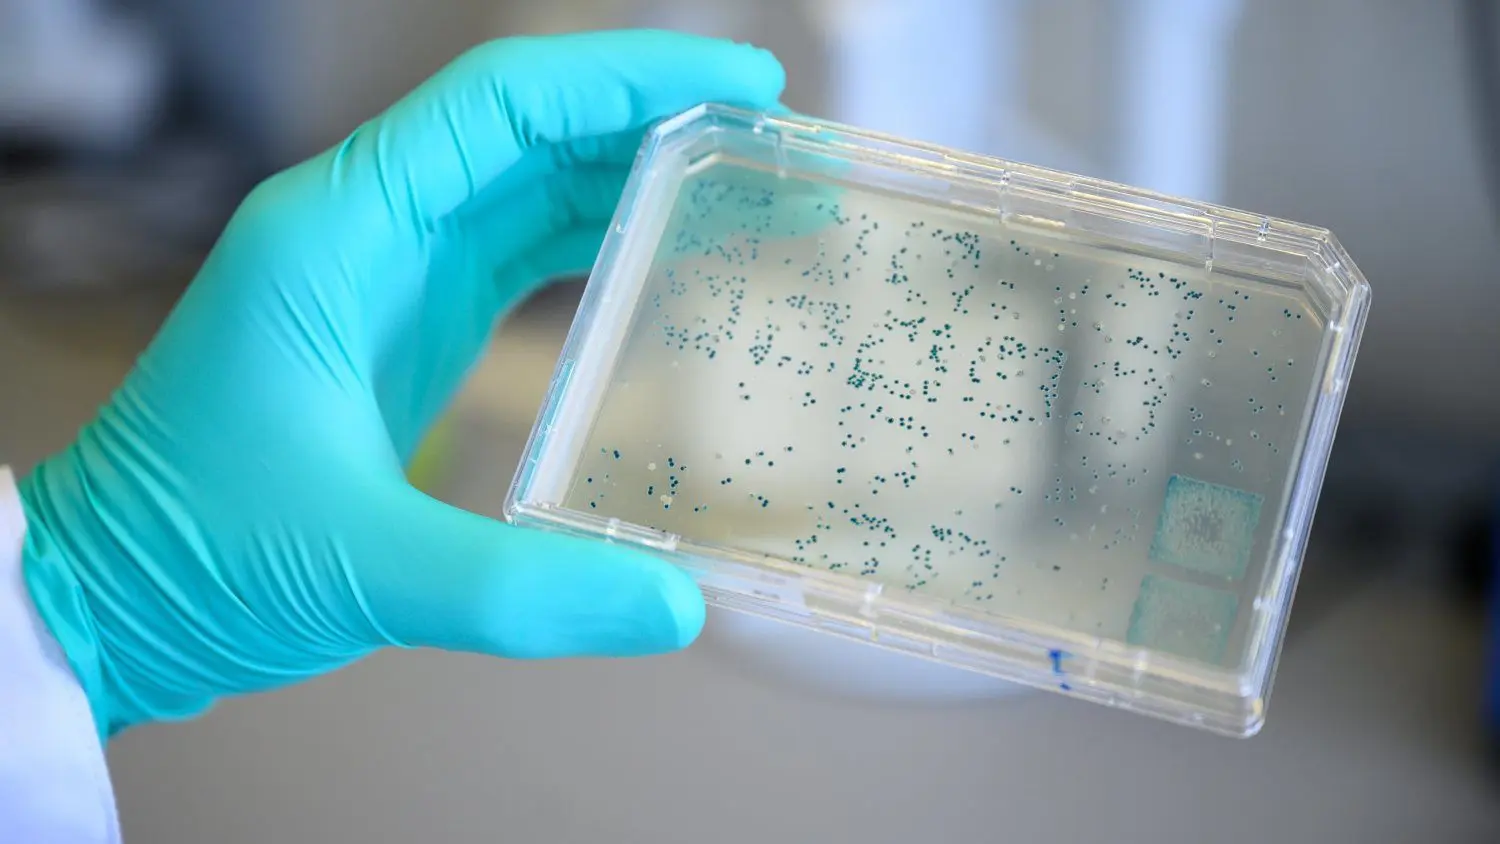

Corona Zahlen NRW: News zu Neuinfektionen mit dem Coronavirus - So hoch sind die Fallzahlen in Nordrhein-Westfalen
Die Neuinfektionen in NRW machen ein Viertel aller Neuinfektionen in Deutschland aus.
Sebastian Gollnow/dpaZwei Corona-Hotspots und deutschlandweit die meisten Infizierten - Nordrhein-Westfalen trifft die zweite Welle der Corona-Pandemie hart. Gut ein Viertel der über 2000 Neuinfektionen, die das Robert Koch-Institut (RKI) am Dienstag für Deutschland gemeldet hat, entfallen auf NRW. Das wichtigste in Kürze:
Das RKI meldet am Dienstag über 500 Neuinfektionen in NRW
Zwei Städte überschreiten den Grenzwert für Maßnahmen.
Corona Zahlen NRW: Diese Fallzahlen meldet das Gesundheitsamt in Nordrhein-Westfalen
Das Ministerium für Arbeit, Gesundheit und Soziales (MAGS) in NordrheinWestfalen gibt täglich die Fallzahlen der Infektionen mit dem Coronavirus bekannt. Diese unterscheiden sich aufgrund von Verzögerungen bei der Übermittlung von denen des RKI.
Diese Zahlen meldete das MAGS am Dienstag:
Zahl der Infizierten seit Beginn der Pandemie: 69.282
Zahl der Toten: 1867
Zahl der Genesenen: 62.052
7-Tage-Inzidenz: 18,9
RKI Zahlen für NRW: So viele Neuinfektionen gibt es in Nordrhein-Westfalen
Das RKI gibt die aktuellen Zahlen der Infektionen mit dem Coronavirus für Bundesländer und Landkreise in einem Dashboard aus. Nach Angaben dieses Dashboard hat Nordrhein-Westfalen hat mit 69.284 nachgewiesenen Fällen seit Beginn der Pandemie die meisten Corona-Fälle. Bayern belegt mit 67.863 den zweiten Platz. In Baden-Württemberg sind seit Beginn der Pandemie 49.2078 Fälle nachgewiesen worden (Stand 29.09., 0:00 Uhr).
So sehen die Zahlen für NRW am Dienstag im Detail aus:
Zahl der Infizierten: 69.284
zahl der Neuinfektionen: 564
Zahl der Toten: 1.867
Zahl der Genesenen: 61.200
Fälle pro 100.000 Einwohner: 386,4
Corona NRW: Hamm und Remscheid weiter über Grenzwert für neue Regeln
Lange war Bayern das Bundesland mit den meisten Corona-Hotspots. Nun hat sich die Situation im Freistaat beruhigt. Dafür steigen die Zahlen in NRW an. Dort überschreiten zwei Städte den bundesweit geltenden Grenzwert von 50 Infektionen pro 100.000 Einwohner über die letzten sieben Tage (7-Tage-Inzidenz).

In Nordrhein-Westfalen überschreiten zwei Städte den Grenzwert.
Screenshot Dashboard RKISo hoch sind die Werte in den Städten in NRW (Stand 29.09, 0:00 Uhr):
Die Stadt Hamm weist mit einem 7-Tage-Inzidenz wert von 98,3 den höchsten Wert aller Städte und Kreise in Deutschland auf.
Auch Remscheid liegt mit 65,8 über dem Grenzwert.
Gelsenkirchen weist einen Wert von 39,5 auf, was zwar unter dem Grenzwert für neue regeln liegt, aber über einer 7-Tage-Inzidenz von 35, die als Vorwarnstufe gilt.
Die Stadt Köln liegt mit 33, 8 knapp darunter.
